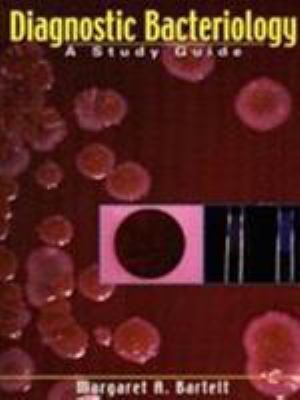
Diagnostic Bacteriology: A Study Guide 0803603010 Book Cover

All Formats & Editions
1 - 1 of 1 results found
Diagnostic Bacteriology: A Study Guide
Edition Description
"Notes" throughout the chapters highlight important facts and suggest memorization tips Line drawings and color plates help students visualize key points Includes a 100-question final exam and glossary Key points for each additional test and culture medium are covered in a comprehensive...
Edition Details
Format:Paperback
Language:English
ISBN:0803603010
Format: Paperback
Condition:
$
93.59
Almost Gone, Only 1 Left!



